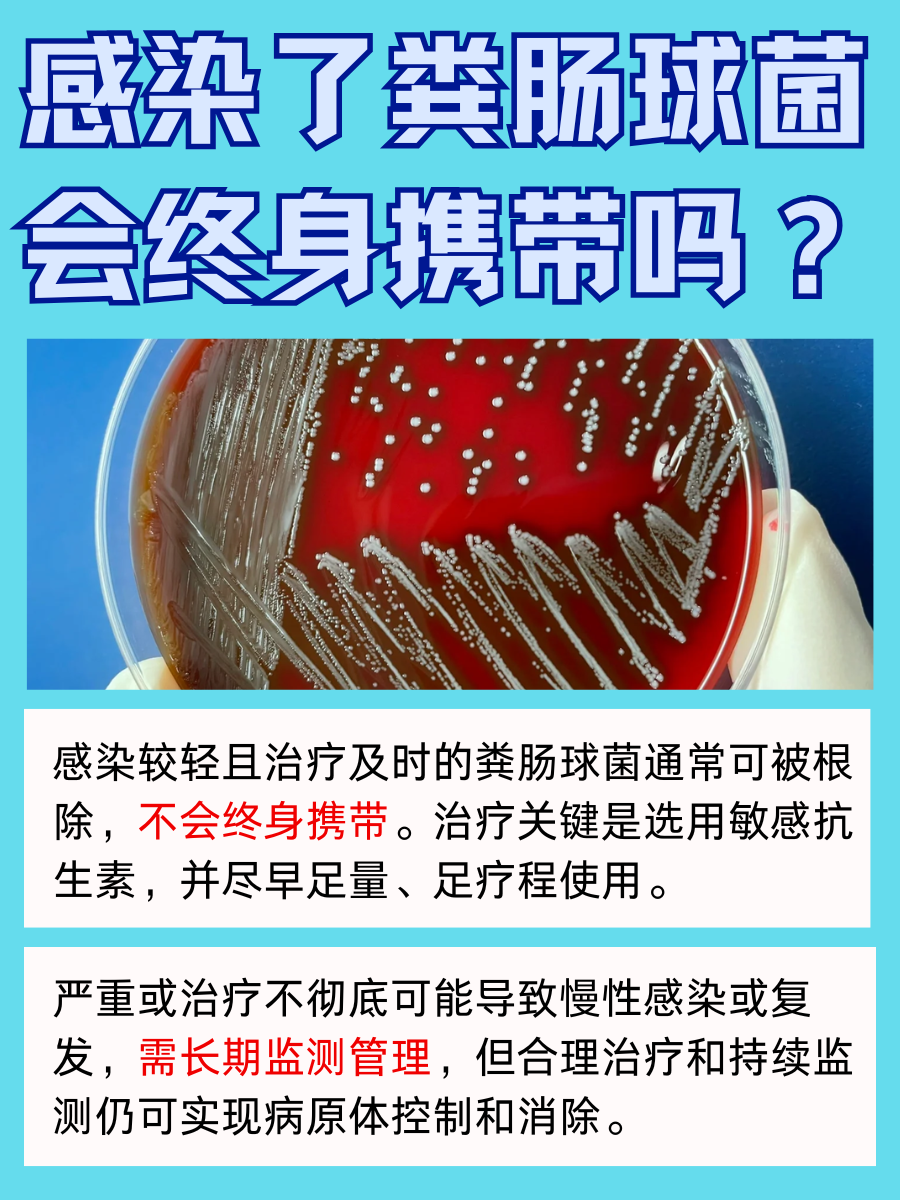
感染粪肠球菌，注定终身携带？未必！

👉在某些情况下,如使用抗生素导致肠道微生物平衡失调,或者当粪肠球菌数量增加或发生变异时,粪肠球菌可能会成为条件致病菌,引发多种感染,如尿路感染、伤口感染、腹膜炎和心内膜炎等。
一旦感染了粪肠球菌,是否意味着要终身携带这种病菌?答案并非绝对,这取决于感染的严重程度和治疗效果。
👀如果感染较轻,并且及时得到治疗,粪肠球菌通常可以被根除,不会终身携带。治疗通常包括选择对粪肠球菌敏感的抗生素,如氨基糖苷类、青霉素类或糖肽类抗生素。治疗的原则是尽早开始足量、足疗程的抗生素治疗,以达到最佳疗效。
然而,如果感染严重或治疗不彻底,可能会导致慢性感染或复发。在这种情况下,可能需要长期监测和管理,甚至可能给人一种“终身携带”的印象。但即便如此,通过合理的治疗和持续的监测,仍然有可能实现病原体的控制和消除。
🌱对于已经感染粪肠球菌的患者,可以在医生指导下积极使用药物治疗。
📍抗生素类药物
🌸青霉素类:氨苄青霉素、青霉素G、阿莫西林、青霉素V钾片等,对粪肠球菌有较好的抗菌作用。但需注意,部分粪肠球菌可能对青霉素产生耐药性。
🌸氨基糖苷类:如庆大霉素、妥布霉素、卡那霉素等,这些药物常与其他抗生素联合使用,以提高治疗效果。但需注意其耳毒性和肾毒性等副作用。
🌸糖肽类:如万古霉素,对粪肠球菌感染有较好的疗效,特别是在其他抗生素耐药的情况下。但万古霉素的使用需严格控制,以避免耐药性的产生。
📍益生菌类药物
如乳酸菌素片、双歧杆菌三联活菌胶囊、枯草杆菌二联活菌颗粒等,这些药物可以改善肠道菌群失调,辅助治疗粪肠球菌感染引起的腹泻、腹胀等不适症状。
🙌同时,患者也要注意生活习惯的调整,详见图~如果你或你的家人曾经感染过粪肠球菌,或者对肠道健康有任何疑问,欢迎在评论区分享自己的经验和看法。